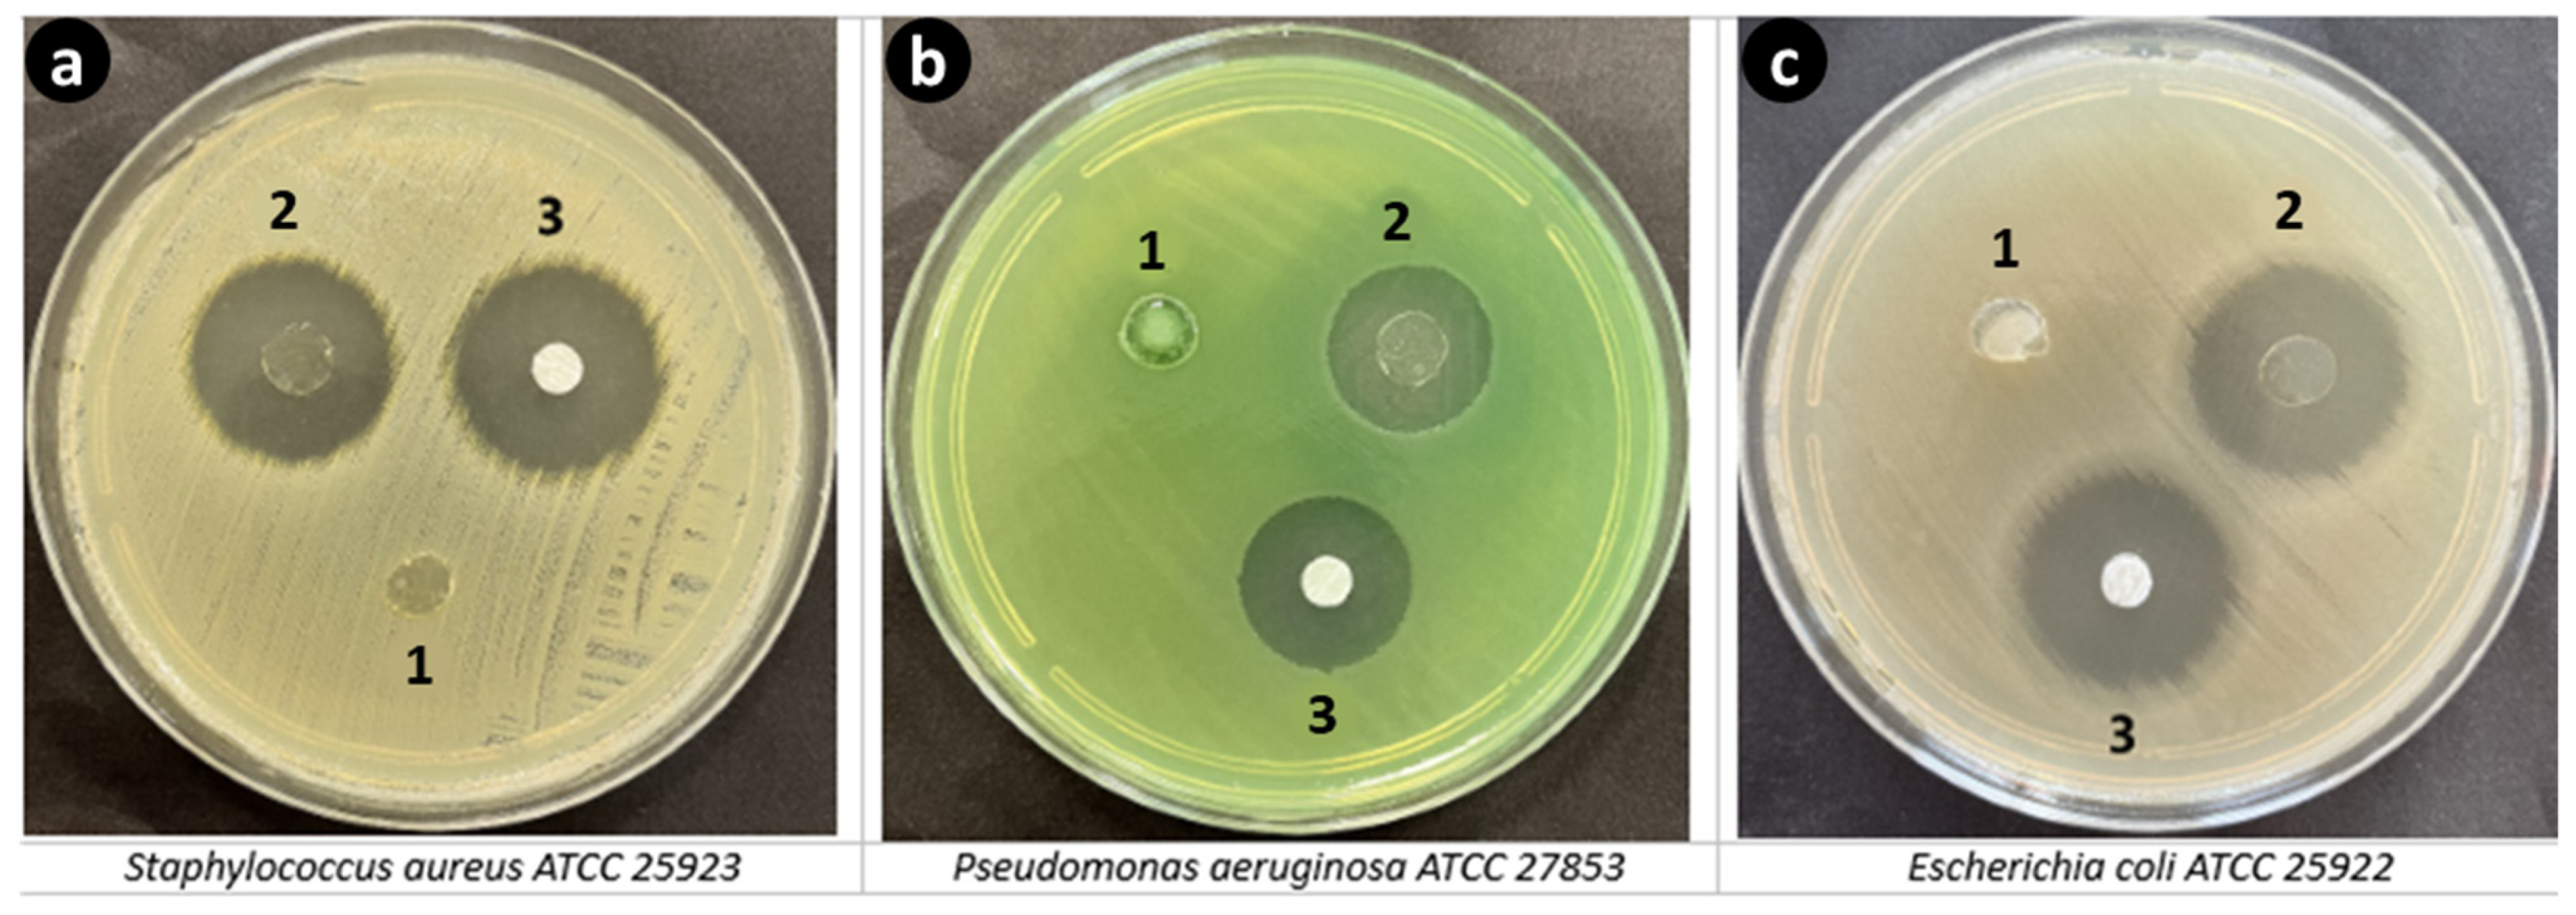

Three-Dimensional-Printed GelMA-KerMA Composite Patches as an Innovative Platform for Potential Tissue Engineering of Tympanic Membrane Perforations
Abstract
1. Introduction
2. Materials and Methods
2.1. Materials
2.2. Synthesis and Characterization of Gelatin Methacryloyl (GelMA)
2.3. Extraction of Keratin from Wool
2.4. Synthesis and Characterization of Keratin Methacryloyl (KerMA)
2.5. Preparation of GelMA-KerMA Composite Ink
2.6. Design and Fabrication of 3D-Printed GelMA-KerMA Patches
2.7. Nanoparticle Coating of GelMA-KerMA Patches by Coaxial Electrospray Method
2.8. Fourier Transform Infrared Spectroscopy (FTIR)
2.9. Morphological Properties of GelMA-KerMA Patches
2.10. Mechanical Characteristics of GelMA-KerMA Hydrogels
2.11. Swelling and Degradation Analysis for GelMA-KerMA Patches
2.12. In Vitro GEN Release Study
2.13. In Vitro FGF-2 Release Study
2.14. GEN Release Kinetics
2.15. In Vitro Antimicrobial Activity
2.16. Cell Culture Studies
2.16.1. Cell Viability
2.16.2. Fluorescence Microscopy Analyses
2.16.3. SEM Characterization
2.17. Statistical Analysis
3. Results and Discussion
3.1. H NMR Analysis of GelMA and KerMA
3.2. Fourier Transform Infrared Spectroscopy (FTIR)
3.3. Morphological Analysis of GelMA-KerMA Patches
3.4. Mechanical Characteristics of GelMA-KerMA Hydrogels
3.5. Swelling and Degradation Analysis for GelMA-KerMA Patches
3.6. In Vitro GEN Release Study
3.7. In Vitro FGF-2 Release Study
3.8. GEN Release Kinetics
3.9. In Vitro Antimicrobial Activity
3.10. Cell Culture Studies
4. Conclusions
Author Contributions
Funding
Data Availability Statement
Acknowledgments
Conflicts of Interest
References
- Anand, S.; Danti, S.; Moroni, L.; Mota, C. Regenerative Therapies for Tympanic Membrane. Prog. Mater. Sci. 2022, 127, 100942. [Google Scholar] [CrossRef]
- Sainsbury, E.; do Amaral, R.; Blayney, A.W.; Walsh, R.M.C.; O’Brien, F.J.; O’Leary, C. Tissue Engineering and Regenerative Medicine Strategies for the Repair of Tympanic Membrane Perforations. Biomater. Biosyst. 2022, 6, 100046. [Google Scholar] [CrossRef] [PubMed]
- Rathnakara, S.H.; Raju, S.R.; Kumar, R.; Hegde, G. Silk Fibroin Nanofiber Scaffold (SFNS) as a Graft Material for Myringoplasty—In Vitro and In Vivo. Materialia 2022, 26, 101562. [Google Scholar] [CrossRef]
- Maharajan, N.; Cho, G.W.; Jang, C.H. Application of Mesenchymal Stem Cell for Tympanic Membrane Regeneration by Tissue Engineering Approach. Int. J. Pediatr. Otorhinolaryngol. 2020, 133, 109969. [Google Scholar] [CrossRef] [PubMed]
- O’Reilly, R.C.; Goldman, S.A.; Widner, S.A.; Cass, S.P. Creating a Stable Tympanic Membrane Perforation Using Mitomycin C. Otolaryngol.-Head Neck Surg. 2001, 124, 40–45. [Google Scholar] [CrossRef]
- Hong, P.; Bance, M.; Gratzer, P.F. Repair of Tympanic Membrane Perforation Using Novel Adjuvant Therapies: A Contemporary Review of Experimental and Tissue Engineering Studies. Int. J. Pediatr. Otorhinolaryngol. 2013, 77, 3–12. [Google Scholar] [CrossRef] [PubMed]
- Merchant, S.N.; McKenna, M.J.; Rosowski, J.J. Current Status and Future Challenges of Tympanoplasty. Eur. Arch. Oto-Rhino-Laryngol. 1998, 255, 221–228. [Google Scholar] [CrossRef] [PubMed]
- Laidlaw, D.W.; Costantino, P.D.; Govindaraj, S.; Hiltzik, D.H.; Catalano, P.J. Tympanic Membrane Repair with a Dermal Allograft. Laryngoscope 2001, 111, 702–707. [Google Scholar] [CrossRef]
- Benecke, J.E.J. Tympanic Membrane Grafting with Alloderm. Laryngoscope 2001, 111, 1525–1527. [Google Scholar] [CrossRef]
- Villar-Fernandez, M.A.; Lopez-Escamez, J.A. Outlook for Tissue Engineering of the Tympanic Membrane. Audiol. Res. 2015, 5, 117. [Google Scholar] [CrossRef]
- Bedir, T.; Ulag, S.; Ustundag, C.B.; Gunduz, O. 3D Bioprinting Applications in Neural Tissue Engineering for Spinal Cord Injury Repair. Mater. Sci. Eng. C 2020, 110, 110741. [Google Scholar] [CrossRef]
- Ligon, S.C.; Liska, R.; Stampfl, J.; Gurr, M.; Mülhaupt, R. Polymers for 3D Printing and Customized Additive Manufacturing. Chem. Rev. 2017, 117, 10212–10290. [Google Scholar] [CrossRef]
- Wu, G.-H.; Hsu, S.-H. Review: Polymeric-Based 3D Printing for Tissue Engineering. J. Med. Biol. Eng. 2015, 35, 285–292. [Google Scholar] [CrossRef]
- Id, P.Z.; Long, W.; Id, N.; An, J.; Chua, C.K.; Poh, L.; Id, T. Layer-by-Layer Ultraviolet Assisted Extrusion-Based (UAE) Bioprinting of Hydrogel Constructs with High Aspect Ratio for Soft Tissue Engineering Applications. PLoS ONE 2019, 14, e0216776. [Google Scholar]
- Ye, W.; Li, H.; Yu, K.; Xie, C.; Wang, P.; Zheng, Y.; Zhang, P.; Xiu, J.; Yang, Y.; Zhang, F.; et al. 3D Printing of Gelatin Methacrylate-Based Nerve Guidance Conduits with Multiple Channels. Mater. Des. 2020, 192, 108757. [Google Scholar] [CrossRef]
- Mathew, E.; Pitzanti, G.; Larrañeta, E.; Lamprou, D.A. 3D Printing of Pharmaceuticals and Drug Delivery Devices. Pharmaceutics 2020, 12, 266. [Google Scholar] [CrossRef] [PubMed]
- Ma, Y.; Wei, W.; Gong, L.; Li, C.; Hong, Y.; Wang, X.; Liang, R.; Shao, Q.; Liang, Q.; Huang, W.; et al. Biomacromolecule-Based Agent for High-Precision Light-Based 3D Hydrogel Bioprinting. Cell Rep. Phys. Sci. 2022, 3, 100985. [Google Scholar] [CrossRef]
- Kim, S.H.; Yeon, Y.K.; Lee, J.M.; Chao, J.R.; Lee, Y.J.; Seo, Y.B.; Sultan, M.T.; Lee, O.J.; Lee, J.S.; Yoon, S., II; et al. Precisely Printable and Biocompatible Silk Fibroin Bioink for Digital Light Processing 3D Printing. Nat. Commun. 2018, 9, 1620. [Google Scholar] [CrossRef]
- Highley, C.B.; Rodell, C.B.; Burdick, J.A. Direct 3D Printing of Shear-Thinning Hydrogels into Self-Healing Hydrogels. Adv. Mater. 2015, 27, 5075–5079. [Google Scholar] [CrossRef] [PubMed]
- Chimene, D.; Kaunas, R.; Gaharwar, A.K. Hydrogel Bioink Reinforcement for Additive Manufacturing: A Focused Review of Emerging Strategies. Adv. Mater. 2020, 32, 1902026. [Google Scholar] [CrossRef] [PubMed]
- Loessner, D.; Meinert, C.; Kaemmerer, E.; Martine, L.C.; Yue, K.; Levett, P.A.; Klein, T.J.; Melchels, F.P.W.; Khademhosseini, A.; Hutmacher, D.W. Functionalization, Preparation and Use of Cell-Laden Gelatin Methacryloyl-Based Hydrogels as Modular Tissue Culture Platforms. Nat. Protoc. 2016, 11, 727–746. [Google Scholar] [CrossRef] [PubMed]
- Zeng, Z.; Jiang, G.; Liu, T.; Song, G.; Sun, Y.; Zhang, X.; Jing, Y.; Feng, M.; Shi, Y. Fabrication of Gelatin Methacryloyl Hydrogel Microneedles for Transdermal Delivery of Metformin in Diabetic Rats. Bio-Design Manuf. 2021, 4, 902–911. [Google Scholar] [CrossRef]
- Song, P.; Li, M.; Zhang, B.; Gui, X.; Han, Y.; Wang, L.; Zhou, W.; Guo, L.; Zhang, Z.; Li, Z.; et al. DLP Fabricating of Precision GelMA/HAp Porous Composite Scaffold for Bone Tissue Engineering Application. Compos. Part B Eng. 2022, 244, 110163. [Google Scholar] [CrossRef]
- Shirahama, H.; Lee, B.H.; Tan, L.P.; Cho, N.J. Precise Tuning of Facile One-Pot Gelatin Methacryloyl (GelMA) Synthesis. Sci. Rep. 2016, 6, 31036. [Google Scholar] [CrossRef]
- Elomaa, L.; Keshi, E.; Sauer, I.M.; Weinhart, M. Development of GelMA/PCL and DECM/PCL Resins for 3D Printing of Acellular In Vitro Tissue Scaffolds by Stereolithography. Mater. Sci. Eng. C Mater. Biol. Appl. 2020, 112, 110958. [Google Scholar] [CrossRef]
- Ramesh, S.; Ramalingam, M. Aqueous-Mediated Synthesis and Characterization of Gelatin Methacryloyl for Biomedical Applications. Biointerface Res. Appl. Chem. 2022, 12, 6269–6279. [Google Scholar] [CrossRef]
- Su, S.; Bedir, T.; Kalkandelen, C.; Turkoglu, H.; Ahmet, S.; Basar, O.; Chen, J. A Drug-Eluting Nanofibrous Hyaluronic Acid-Keratin Mat for Diabetic Wound Dressing. Emergent Mater. 2022, 5, 1617–1627. [Google Scholar] [CrossRef]
- Salama, A.; Guarino, V. Ionic Liquids to Process Silk Fibroin and Wool Keratin for Bio-Sustainable and Biomedical Applications. J. Polym. Environ. 2022, 30, 4961–4977. [Google Scholar] [CrossRef]
- Sanchez Ramirez, D.O.; Vineis, C.; Cruz-Maya, I.; Tonetti, C.; Guarino, V.; Varesano, A. Wool Keratin Nanofibers for Bioinspired and Sustainable Use in Biomedical Field. J. Funct. Biomater. 2023, 14, 5. [Google Scholar] [CrossRef]
- Wang, X.; Shi, Z.; Tian, Z.; Tang, H.; Li, Q.; Shen, X. Molecular Mechanism of Rabbit Hair Keratin Hydrogel Fabricated via Cryoablation. Macromol. Chem. Phys. 2021, 222, 2100240. [Google Scholar] [CrossRef]
- Su, S.; Bedir, T.; Kalkandelen, C.; Bas, A.O.; Gunduz, O. Coaxial and Emulsion Electrospinning of Extracted Hyaluronic Acid and Keratin Based Nanofibers for Wound Healing Applications. Eur. Polym. J. 2021, 142, 110158. [Google Scholar] [CrossRef]
- Lou, Z.-C.; Lou, Z.-H.; Xiao, J. Regeneration of the Tympanic Membrane Using Fibroblast Growth Factor-2. J. Laryngol. Otol. 2018, 132, 470–478. [Google Scholar] [CrossRef]
- Lou, Z.; Xu, L.; Yang, J.; Wu, X. Outcome of Children with Edge-Everted Traumatic Tympanic Membrane Perforations Following Spontaneous Healing versus Fibroblast Growth Factor-Containing Gelfoam Patching with or without Edge Repair. Int. J. Pediatr. Otorhinolaryngol. 2011, 75, 1285–1288. [Google Scholar] [CrossRef] [PubMed]
- Kanemaru, S.-I.; Umeda, H.; Kitani, Y.; Nakamura, T.; Hirano, S.; Ito, J. Regenerative Treatment for Tympanic Membrane Perforation. Otol. Neurotol. 2011, 32, 1218–1223. [Google Scholar] [CrossRef]
- Zhang, L.; Huang, J.; Si, T.; Xu, R.X. Coaxial Electrospray of Microparticles and Nanoparticles for Biomedical Applications. Expert Rev. Med. Devices 2012, 9, 595–612. [Google Scholar] [CrossRef] [PubMed]
- Felice, B.; Prabhakaran, M.P.; Zamani, M.; Rodríguez, A.P.; Ramakrishna, S. Electrosprayed Poly(Vinyl Alcohol) Particles: Preparation and Evaluation of Their Drug Release Profile. Polym. Int. 2015, 64, 1722–1732. [Google Scholar] [CrossRef]
- Gao, P.; Nie, X.; Zou, M.; Shi, Y.; Cheng, G. Recent Advances in Materials for Extended-Release Antibiotic Delivery System. J. Antibiot. 2011, 64, 625–634. [Google Scholar] [CrossRef]
- Qi, X.; Qin, X.; Yang, R.; Qin, J.; Li, W.; Luan, K.; Wu, Z.; Song, L. Intra-Articular Administration of Chitosan Thermosensitive In Situ Hydrogels Combined with Diclofenac Sodium–Loaded Alginate Microspheres. J. Pharm. Sci. 2016, 105, 122–130. [Google Scholar] [CrossRef]
- Imbuluzqueta, E.; Elizondo, E.; Gamazo, C.; Moreno-Calvo, E.; Veciana, J.; Ventosa, N.; Blanco-Prieto, M.J. Novel Bioactive Hydrophobic Gentamicin Carriers for the Treatment of Intracellular Bacterial Infections. Acta Biomater. 2011, 7, 1599–1608. [Google Scholar] [CrossRef]
- Dorati, R.; DeTrizio, A.; Spalla, M.; Migliavacca, R.; Pagani, L.; Pisani, S.; Chiesa, E.; Conti, B.; Modena, T.; Genta, I. Gentamicin Sulfate PEG-PLGA/PLGA-H Nanoparticles: Screening Design and Antimicrobial Effect Evaluation toward Clinic Bacterial Isolates. Nanomaterials 2018, 8, 37. [Google Scholar] [CrossRef] [PubMed]
- Tao, G.; Wang, Y.; Cai, R.; Chang, H.; Song, K.; Zuo, H.; Zhao, P.; Xia, Q.; He, H. Design and Performance of Sericin/Poly(Vinyl Alcohol) Hydrogel as a Drug Delivery Carrier for Potential Wound Dressing Application. Mater. Sci. Eng. C 2019, 101, 341–351. [Google Scholar] [CrossRef]
- Zhao, S.; Huang, C.; Yue, X.; Li, X.; Zhou, P.; Wu, A.; Chen, C.; Qu, Y.; Zhang, C. Application Advance of Electrosprayed Micro/Nanoparticles Based on Natural or Synthetic Polymers for Drug Delivery System. Mater. Des. 2022, 220, 110850. [Google Scholar] [CrossRef]
- Mandegari, M.; Ghasemi-Mobarakeh, L.; Zamani, M. Manipulating the Degradation Rate of PVA Nanoparticles by a Novel Chemical-Free Method. Polym. Adv. Technol. 2019, 30, 2381–2391. [Google Scholar] [CrossRef]
- Asadi, M.; Salami, M.; Hajikhani, M.; Emam-Djomeh, Z.; Aghakhani, A.; Ghasemi, A. Electrospray Production of Curcumin-Walnut Protein Nanoparticles. Food Biophys. 2021, 16, 15–26. [Google Scholar] [CrossRef]
- Luo, C.J.; Okubo, T.; Nangrejo, M.; Edirisinghe, M. Preparation of Polymeric Nanoparticles by Novel Electrospray Nanoprecipitation. Polym. Int. 2015, 64, 183–187. [Google Scholar] [CrossRef]
- Hao, S.; Wang, B.; Wang, Y.; Xu, Y. Enteric-Coated Sustained-Release Nanoparticles by Coaxial Electrospray: Preparation, Characterization, and In Vitro Evaluation. J. Nanoparticle Res. 2014, 16, 2204. [Google Scholar] [CrossRef]
- Wang, K.; Li, R.; Ma, J.; Jian, Y.; Che, J. Extracting Keratin from Wool by Using L-Cysteine. Green Chem. 2015, 18, 476–481. [Google Scholar] [CrossRef]
- He, J.; Xu, D.; Li, J.; Li, L.; Li, W.; Cui, W.; Liu, K. Highly Efficient Extraction of Large Molecular-Weight Keratin from Wool in a Water/Ethanol Co-Solvent. Text. Res. J. 2019, 90, 1084–1093. [Google Scholar] [CrossRef]
- Erşen Dudu, T.; Alpaslan, D. Eco-Friendly and Biodegradable Dimethylacrylamide/Starch Hydrogels for Controlled Release of Urea and Its Water Retention. MANAS J. Eng. 2022, 10, 116–128. [Google Scholar] [CrossRef]
- Peppas, N.A.; Franson, N.M. The Swelling Interface Number as a Criterion for Prediction of Diffusional Solute Release Mechanisms in Swellable Polymers. J. Polym. Sci. Polym. Phys. Ed. 1983, 21, 983–997. [Google Scholar] [CrossRef]
- Adnadjevic, B.; Jovanovic, J. Novel Approach in Investigation of the Poly(Acrylic Acid) Hydrogel Swelling Kinetics in Water. J. Appl. Polym. Sci. 2008, 107, 3579–3587. [Google Scholar] [CrossRef]
- Insel, M.A.; Karakuş, S.; Temelcan, G.; Kocken, H.G.; Albayrak, I. Handling Uncertainty in Rheological Properties of Green Eggshell Nanocomposites by a Fuzzy-Hybrid Modeling Approach: A Comparative Study. Phys. Scr. 2023, 98, 35001. [Google Scholar] [CrossRef]
- Akoglu, H. User’s Guide to Correlation Coefficients. Turkish J. Emerg. Med. 2018, 18, 91–93. [Google Scholar] [CrossRef]
- Baykara, D.; Bedir, T.; Ilhan, E.; Mutlu, M.E.; Gunduz, O.; Narayan, R.; Ustundag, C.B. Fabrication and Optimization of 3D Printed Gelatin Methacryloyl Microneedle Arrays Based on Vat Photopolymerization. Front. Bioeng. Biotechnol. 2023, 11, 1157541. [Google Scholar] [CrossRef]
- Lai, T.C.; Yu, J.; Tsai, W.B. Gelatin Methacrylate/Carboxybetaine Methacrylate Hydrogels with Tunable Crosslinking for Controlled Drug Release. J. Mater. Chem. B 2016, 4, 2304–2313. [Google Scholar] [CrossRef]
- Raveendran, N.; Meinert, C.; Ipe, D.; Ivanovski, S. Optimization of 3D Bioprinting of Periodontal Ligament Cells. Dent. Mater. 2019, 35, 1683–1694. [Google Scholar] [CrossRef]
- Zheng, J.; Zhu, M.; Ferracci, G.; Cho, N.-J.; Lee, B.H. Hydrolytic Stability of Methacrylamide and Methacrylate in Gelatin Methacryloyl and Decoupling of Gelatin Methacrylamide from Gelatin Methacryloyl through Hydrolysis. Macromol. Chem. Phys. 2018, 219, 1800266. [Google Scholar] [CrossRef]
- Hoch, E.; Schuh, C.; Hirth, T.; Tovar, G.E.M.; Borchers, K. Stiff Gelatin Hydrogels Can Be Photo-Chemically Synthesized from Low Viscous Gelatin Solutions Using Molecularly Functionalized Gelatin with a High Degree of Methacrylation. J. Mater. Sci. Mater. Med. 2012, 23, 2607–2617. [Google Scholar] [CrossRef]
- Erkus, H.; Bedir, T.; Kaya, E.; Tinaz, G.B.; Gunduz, O.; Chifiriuc, M.-C.; Ustundag, C.B. Innovative Transdermal Drug Delivery System Based on Amoxicillin-Loaded Gelatin Methacryloyl Microneedles Obtained by 3D Printing. Materialia 2023, 27, 101700. [Google Scholar] [CrossRef]
- Aldana, A.A.; Malatto, L.; Rehman, M.A.; Boccaccini, A.R.; Abraham, G.A. Fabrication of Gelatin Methacrylate (GelMA) Scaffolds with Nano- and Micro-Topographical and Morphological Features. Nanomaterials 2019, 9, 120. [Google Scholar] [CrossRef]
- Edwards, H.G.M.; Hunt, D.E.; Sibley, M.G. FT-Raman Spectroscopic Study of Keratotic Materials: Horn, Hoof and Tortoiseshell. Spectrochim. Acta Part A Mol. Biomol. Spectrosc. 1998, 54, 745–757. [Google Scholar] [CrossRef]
- Ma, B.; Qiao, X.; Hou, X.; Yang, Y. Pure Keratin Membrane and Fibers from Chicken Feather. Int. J. Biol. Macromol. 2016, 89, 614–621. [Google Scholar] [CrossRef]
- Sharma, S.; Gupta, A.; Nadda, A.; Chua, G.K.; Kamyab, H.; Saufi, S. An Efficient Conversion of Waste Feather Keratin into Ecofriendly Bioplastic Film. Clean Technol. Environ. Policy 2018, 20, 2157–2167. [Google Scholar] [CrossRef]
- Arica, T.A.; Guzelgulgen, M.; Yildiz, A.A.; Demir, M.M. Electrospun GelMA Fibers and p(HEMA) Matrix Composite for Corneal Tissue Engineering. Mater. Sci. Eng. C 2021, 120, 111720. [Google Scholar] [CrossRef]
- Van der Jeught, S.; Dirckx, J.J.J.; Aerts, J.R.M.; Bradu, A.; Podoleanu, A.G.H.; Buytaert, J.A.N. Full-Field Thickness Distribution of Human Tympanic Membrane Obtained with Optical Coherence Tomography. J. Assoc. Res. Otolaryngol. 2013, 14, 483–494. [Google Scholar] [CrossRef]
- Volandri, G.; Di Puccio, F.; Forte, P.; Carmignani, C. Biomechanics of the Tympanic Membrane. J. Biomech. 2011, 44, 1219–1236. [Google Scholar] [CrossRef]
- von Witzleben, M.; Stoppe, T.; Ahlfeld, T.; Bernhardt, A.; Polk, M.-L.; Bornitz, M.; Neudert, M.; Gelinsky, M. Biomimetic Tympanic Membrane Replacement Made by Melt Electrowriting. Adv. Healthc. Mater. 2021, 10, 2002089. [Google Scholar] [CrossRef]
- Tsai, S.; Ting, Y. Synthesize of Alginate/Chitosan Bilayer Nanocarrier by CCD-RSM Guided Co-Axial Electrospray: A Novel and Versatile Approach. Food Res. Int. 2019, 116, 1163–1172. [Google Scholar] [CrossRef]
- Cui, X.; Li, X.; Xu, Z.; Guan, X.; Ma, J.; Ding, D.; Zhang, W. Fabrication and Characterization of Chitosan/Poly(Lactic-Co-Glycolic Acid) Core-Shell Nanoparticles by Coaxial Electrospray Technology for Dual Delivery of Natamycin and Clotrimazole. Front. Bioeng. Biotechnol. 2021, 9, 635485. [Google Scholar] [CrossRef]
- Dwivedi, P.; Yuan, S.; Han, S.; Mangrio, F.A.; Zhu, Z.; Lei, F.; Ming, Z.; Cheng, L.; Liu, Z.; Si, T.; et al. Core–Shell Microencapsulation of Curcumin in PLGA Microparticles: Programmed for Application in Ovarian Cancer Therapy. Artif. Cells Nanomed. Biotechnol. 2018, 46, 481–491. [Google Scholar] [CrossRef]
- Choi, E.; Kim, D.; Kang, D.; Yang, G.H.; Jung, B.; Yeo, M.; Park, M.-J.; An, S.; Lee, K.; Kim, J.S.; et al. 3D-Printed Gelatin Methacrylate (GelMA)/Silanated Silica Scaffold Assisted by Two-Stage Cooling System for Hard Tissue Regeneration. Regen. Biomater. 2021, 8, rbab001. [Google Scholar] [CrossRef]
- Nazir, F.; Ashraf, I.; Iqbal, M.; Ahmad, T.; Anjum, S. 6-Deoxy-Aminocellulose Derivatives Embedded Soft Gelatin Methacryloyl (GelMA) Hydrogels for Improved Wound Healing Applications: In Vitro and in Vivo Studies. Int. J. Biol. Macromol. 2021, 185, 419–433. [Google Scholar] [CrossRef]
- Su, J.; Lin, C.-H.; Chen, H.; Lee, S.-Y.; Lin, Y.-M. Biofabrication of Cell-Laden Gelatin Methacryloyl Hydrogels with Incorporation of Silanized Hydroxyapatite by Visible Light Projection. Polymers 2021, 13, 2354. [Google Scholar] [CrossRef]
- Maharjan, B.; Kumar, D.; Awasthi, G.P.; Bhattarai, D.P.; Kim, J.Y.; Park, C.H.; Kim, C.S. Synthesis and Characterization of Gold/Silica Hybrid Nanoparticles Incorporated Gelatin Methacrylate Conductive Hydrogels for H9C2 Cardiac Cell Compatibility Study. Compos. Part B Eng. 2019, 177, 107415. [Google Scholar] [CrossRef]
- Elkhoury, K.; Sanchez-Gonzalez, L.; Lavrador, P.; Almeida, R.; Gaspar, V.; Kahn, C.; Cleymand, F.; Arab-Tehrany, E.; Mano, J.F. Gelatin Methacryloyl (Gelma) Nanocomposite Hydrogels Embedding Bioactive Naringin Liposomes. Polymers 2020, 12, 2944. [Google Scholar] [CrossRef]
- Gu, L.; Li, T.; Song, X.; Yang, X.; Li, S.; Chen, L.; Liu, P.; Gong, X.; Chen, C.; Sun, L. Preparation and Characterization of Methacrylated Gelatin/Bacterial Cellulose Composite Hydrogels for Cartilage Tissue Engineering. Regen. Biomater. 2021, 7, 195–202. [Google Scholar] [CrossRef]
- Yoon, H.J.; Shin, S.R.; Cha, J.M.; Lee, S.-H.; Kim, J.-H.; Do, J.T.; Song, H.; Bae, H. Cold Water Fish Gelatin Methacryloyl Hydrogel for Tissue Engineering Application. PLoS ONE 2016, 11, e0163902. [Google Scholar] [CrossRef]
- He, J.; Sun, Y.; Gao, Q.; He, C.; Yao, K.; Wang, T.; Xie, M.; Yu, K.; Nie, J.; Chen, Y.; et al. Gelatin Methacryloyl Hydrogel, from Standardization, Performance, to Biomedical Application. Adv. Healthc. Mater. 2023, 12, 2300395. [Google Scholar] [CrossRef]
- Browning, M.B.; Cosgriff-Hernandez, E. Development of a Biostable Replacement for PEGDA Hydrogels. Biomacromolecules 2012, 13, 779–786. [Google Scholar] [CrossRef]
- Rivera-Hernández, G.; Antunes-Ricardo, M.; Martínez-Morales, P.; Sánchez, M.L. Polyvinyl Alcohol Based-Drug Delivery Systems for Cancer Treatment. Int. J. Pharm. 2021, 600, 120478. [Google Scholar] [CrossRef]
- Arshad, M.S.; Zafar, S.; Rana, S.J.; Nazari, K.; Chang, M.-W.; Ahmad, Z. Fabrication of Gentamicin Sulphate Laden Stimulus Responsive Polymeric Microarray Patches for the Treatment of Bacterial Biofilms. J. Drug Deliv. Sci. Technol. 2023, 84, 104504. [Google Scholar] [CrossRef]
- Hamdan, N.; Susanti, D.; Wan Abdul Khodir, W. In Vitro Evaluation of Crosslinked Polyvinyl Alcohol/Chitosan-Gentamicin Sulfate Electrospun Nanofibers. Malays. J. Chem. 2021, 23, 1–10. [Google Scholar]
- Flores-Arriaga, J.C.; Chavarría-Bolaños, D.; Pozos-Guillén, A.D.J.; Escobar-Barrios, V.A.; Cerda-Cristerna, B.I. Synthesis of a PVA Drug Delivery System for Controlled Release of a Tramadol–Dexketoprofen Combination. J. Mater. Sci. Mater. Med. 2021, 32, 56. [Google Scholar] [CrossRef] [PubMed]
- Shurshina, A.S.; Lazdin, R.Y.; Zakharova, E.M.; Titlova, A.S.; Kulish, E.I. Prolonging Effects of Polyvinyl Alcohol on Drug Release. Chim. Techno Acta 2022, 9, 20229206. [Google Scholar] [CrossRef]
- Singh, R.; Lillard, J.W.J. Nanoparticle-Based Targeted Drug Delivery. Exp. Mol. Pathol. 2009, 86, 215–223. [Google Scholar] [CrossRef] [PubMed]
- Xiang, L.; Cui, W. Biomedical Application of Photo-Crosslinked Gelatin Hydrogels. J. Leather Sci. Eng. 2021, 3, 3. [Google Scholar] [CrossRef]
- Zhang, K.; Yang, J.; Sun, Y.; Wang, Y.; Liang, J.; Luo, J.; Cui, W.; Deng, L.; Xu, X.; Wang, B.; et al. Gelatin-Based Composite Hydrogels with Biomimetic Lubrication and Sustained Drug Release. Friction 2022, 10, 232–246. [Google Scholar] [CrossRef]
- Maleki Dizaj, S.; Lotfipour, F.; Barzegar-Jalali, M.; Zarrintan, M.-H.; Adibkia, K. Physicochemical Characterization and Antimicrobial Evaluation of Gentamicin-Loaded CaCO3 Nanoparticles Prepared via Microemulsion Method. J. Drug Deliv. Sci. Technol. 2016, 35, 16–23. [Google Scholar] [CrossRef]
- Abdel-Hakeem, M.A.; Abdel Maksoud, A.I.; Aladhadh, M.A.; Almuryif, K.A.; Elsanhoty, R.M.; Elebeedy, D. Gentamicin–Ascorbic Acid Encapsulated in Chitosan Nanoparticles Improved In Vitro Antimicrobial Activity and Minimized Cytotoxicity. Antibiotics 2022, 11, 1530. [Google Scholar] [CrossRef] [PubMed]
- Li, S.; Li, W.; Prausnitz, M. Individually Coated Microneedles for Co-Delivery of Multiple Compounds with Different Properties. Drug Deliv. Transl. Res. 2018, 8, 1043–1052. [Google Scholar] [CrossRef]
- Ali, R.; Mehta, P.; Kyriaki Monou, P.; Arshad, M.S.; Panteris, E.; Rasekh, M.; Singh, N.; Qutachi, O.; Wilson, P.; Tzetzis, D.; et al. Electrospinning/Electrospraying Coatings for Metal Microneedles: A Design of Experiments (DOE) and Quality by Design (QbD) Approach. Eur. J. Pharm. Biopharm. 2020, 156, 20–39. [Google Scholar] [CrossRef]
- Lee, Y.-H.; Lin, S.-J. Chitosan/PVA Hetero-Composite Hydrogel Containing Antimicrobials, Perfluorocarbon Nanoemulsions, and Growth Factor-Loaded Nanoparticles as a Multifunctional Dressing for Diabetic Wound Healing: Synthesis, Characterization, and In Vitro/In Vivo Evaluation. Pharmaceutics 2022, 14, 537. [Google Scholar] [CrossRef]
- Mabilleau, G.; Aguado, E.; Stancu, I.C.; Cincu, C.; Baslé, M.F.; Chappard, D. Effects of FGF-2 Release from a Hydrogel Polymer on Bone Mass and Microarchitecture. Biomaterials 2008, 29, 1593–1600. [Google Scholar] [CrossRef]
- Fathi, E.; Nassiri, S.M.; Atyabi, N.; Ahmadi, S.H.; Imani, M.; Farahzadi, R.; Rabbani, S.; Akhlaghpour, S.; Sahebjam, M.; Taheri, M. Induction of Angiogenesis via Topical Delivery of Basic-Fibroblast Growth Factor from Polyvinyl Alcohol–Dextran Blend Hydrogel in an Ovine Model of Acute Myocardial Infarction. J. Tissue Eng. Regen. Med. 2013, 7, 697–707. [Google Scholar] [CrossRef]
- Luo, L.; He, Y.; Jin, L.; Zhang, Y.; Guastaldi, F.P.; Albashari, A.A.; Hu, F.; Wang, X.; Wang, L.; Xiao, J.; et al. Application of Bioactive Hydrogels Combined with Dental Pulp Stem Cells for the Repair of Large Gap Peripheral Nerve Injuries. Bioact. Mater. 2021, 6, 638–654. [Google Scholar] [CrossRef] [PubMed]
- Tut, T.A.; Cesur, S.; Ilhan, E.; Sahin, A.; Yildirim, O.S.; Gunduz, O. Gentamicin-Loaded Polyvinyl Alcohol/Whey Protein Isolate/Hydroxyapatite 3D Composite Scaffolds with Drug Delivery Capability for Bone Tissue Engineering Applications. Eur. Polym. J. 2022, 179, 111580. [Google Scholar] [CrossRef]
- Shabbir, M.; Ali, S.; Hamid, I.; Sharif, A.; Akhtar, M.F.; Raza, M.; Ahmed, S.; Peerzada, S.; Amin, M.U. Influence of Different Formulation Variables on the Performance of Transdermal Drug Delivery System Containing Tizanidine Hydrochloride: In Vitro and Ex Vivo Evaluations. Braz. J. Pharm. Sci. 2018, 54, e00130. [Google Scholar] [CrossRef]
- Guo, J.; Zhu, Y.; Miao, P. Nano-Impact Electrochemical Biosensing Based on a CRISPR-Responsive DNA Hydrogel. Nano Lett. 2023, 23, 11099–11104. [Google Scholar] [CrossRef]
- Nazemi, N.; Rajabi, N.; Aslani, Z.; Kharaziha, M.; Kasiri-Asgarani, M.; Bakhsheshi-Rad, H.R.; Najafinezhad, A.; Ismail, A.F.; Sharif, S.; Berto, F. Synthesis and Characterization of Gentamicin Loaded ZSM-5 Scaffold: Cytocompatibility and Antibacterial Activity. J. Biomater. Appl. 2023, 37, 979–991. [Google Scholar] [CrossRef] [PubMed]
- Bakhsheshi-Rad, H.R.; Hamzah, E.; Ismail, A.F.; Aziz, M.; Hadisi, Z.; Kashefian, M.; Najafinezhad, A. Novel Nanostructured Baghdadite-Vancomycin Scaffolds: In-Vitro Drug Release, Antibacterial Activity and Biocompatibility. Mater. Lett. 2017, 209, 369–372. [Google Scholar] [CrossRef]
- Xiao, Z.; Zheng, X.; An, Y.; Wang, K.; Zhang, J.; He, H.; Wu, J. Zwitterionic Hydrogel for Sustained Release of Growth Factors to Enhance Wound Healing. Biomater. Sci. 2021, 9, 882–891. [Google Scholar] [CrossRef] [PubMed]
- Gentile, F.; Tirinato, L.; Battista, E.; Causa, F.; Liberale, C.; di Fabrizio, E.M.; Decuzzi, P. Cells Preferentially Grow on Rough Substrates. Biomaterials 2010, 31, 7205–7212. [Google Scholar] [CrossRef] [PubMed]

| Samples | Process | Shell | Core |
|---|---|---|---|
| GelMA-KerMA | - | - | - |
| GEN@PVA/GelMA-KerMA | Single | 1% (w/v) PVA 0.2% (w/v) GEN | - |
| FGF-2@PVA/GelMA-KerMA | Single | 1% (w/v) PVA FGF-2 (100 ng/mL) | - |
| FGF-2@GEN@PVA/GelMA-KerMA | Coaxial | 1% (w/v) PVA 0.2% (w/v) GEN | 1% (w/v) PVA FGF-2 (100 ng/mL) |
| Hydrogels | Model Parameters | Performance Metrics | |||
|---|---|---|---|---|---|
| Se (%) | ks (minm) | m | R2 | RMSE | |
| GelMA-KerMA | 579.79 | 872.65 | 0.6167 | 0.9668 | 21.39 |
| GEN@PVA/GelMA-KerMA | 541.46 | 843.30 | 0.6625 | 0.9780 | 26.76 |
| FGF-2@PVA/GelMA-KerMA | 519.20 | 1117.2 | 0.8453 | 0.9673 | 19.69 |
| FGF-2@GEN@PVA/GelMA-KerMA | 493.31 | 1486.6 | 1.0061 | 0.9665 | 20.71 |
| Korsmeyer-Peppas | Zero-Order | First-Order | Higuchi | Hixson-Crowell | ||||||
|---|---|---|---|---|---|---|---|---|---|---|
| R2 | n | R2 | K0 | R2 | K1 | R2 | Kh | R2 | Khc | |
| GEN@PVA/GelMA-KerMA | 0.9758 | 39.054 | 0.71 | 0.5061 | 0.9531 | −0.01 | 0.943 | 13.7 | 0.9351 | 0.0228 |
| The Ranges of n Values | Transport Mechanisms |
|---|---|
| 0.45 ≤ n | Fickian diffusion mechanism |
| 0.45 < n < 0.89 | Non-Fickian transport |
| n = 0.89 | Case II (relaxational) transport |
| n > 0.89 | Super Case II transport |
| Blank GelMA-KerMA | GEN@PVA/GelMA-KerMA (15 µg) | GEN (10 µg Disc) | |
|---|---|---|---|
| S. aureus 25923 | - | 25 | 25 |
| P. aeruginosa 27853 | - | 20 | 21 |
| E. coli 25922 | - | 25 | 26 |
Disclaimer/Publisher’s Note: The statements, opinions and data contained in all publications are solely those of the individual author(s) and contributor(s) and not of MDPI and/or the editor(s). MDPI and/or the editor(s) disclaim responsibility for any injury to people or property resulting from any ideas, methods, instructions or products referred to in the content. |
© 2024 by the authors. Licensee MDPI, Basel, Switzerland. This article is an open access article distributed under the terms and conditions of the Creative Commons Attribution (CC BY) license (https://creativecommons.org/licenses/by/4.0/).
Share and Cite
Bedir, T.; Baykara, D.; Yildirim, R.; Calikoglu Koyuncu, A.C.; Sahin, A.; Kaya, E.; Tinaz, G.B.; Insel, M.A.; Topuzogulları, M.; Gunduz, O.; et al. Three-Dimensional-Printed GelMA-KerMA Composite Patches as an Innovative Platform for Potential Tissue Engineering of Tympanic Membrane Perforations. Nanomaterials 2024, 14, 563. https://doi.org/10.3390/nano14070563
Bedir T, Baykara D, Yildirim R, Calikoglu Koyuncu AC, Sahin A, Kaya E, Tinaz GB, Insel MA, Topuzogulları M, Gunduz O, et al. Three-Dimensional-Printed GelMA-KerMA Composite Patches as an Innovative Platform for Potential Tissue Engineering of Tympanic Membrane Perforations. Nanomaterials. 2024; 14(7):563. https://doi.org/10.3390/nano14070563
Chicago/Turabian StyleBedir, Tuba, Dilruba Baykara, Ridvan Yildirim, Ayse Ceren Calikoglu Koyuncu, Ali Sahin, Elif Kaya, Gulgun Bosgelmez Tinaz, Mert Akin Insel, Murat Topuzogulları, Oguzhan Gunduz, and et al. 2024. "Three-Dimensional-Printed GelMA-KerMA Composite Patches as an Innovative Platform for Potential Tissue Engineering of Tympanic Membrane Perforations" Nanomaterials 14, no. 7: 563. https://doi.org/10.3390/nano14070563
APA StyleBedir, T., Baykara, D., Yildirim, R., Calikoglu Koyuncu, A. C., Sahin, A., Kaya, E., Tinaz, G. B., Insel, M. A., Topuzogulları, M., Gunduz, O., Ustundag, C. B., & Narayan, R. (2024). Three-Dimensional-Printed GelMA-KerMA Composite Patches as an Innovative Platform for Potential Tissue Engineering of Tympanic Membrane Perforations. Nanomaterials, 14(7), 563. https://doi.org/10.3390/nano14070563

